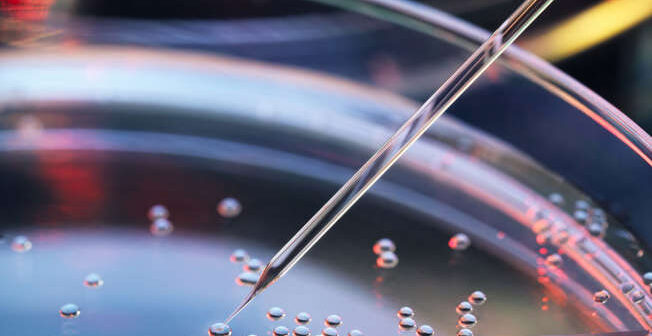
professor Shoukhrat Mitalipov

Revolução genética: cientistas desenvolvem embriões a partir de células da pele
Pele
Cientistas da Universidade de Saúde e Ciência do Oregon, em Portland (EUA), conseguiram criar, pela primeira vez, embriões a partir de células humanas fertilizadas com espermatozoides.
O dom da vida
Pais alternativos
O mesmo princípio também poderia ser aplicado a casais do mesmo s e x o, possibilitando gerar filhos com o DNA de ambos.
Células da pele
Ainda em estágio inicial

Cientistas da Universidade de Saúde e Ciência do Oregon, em Portland (EUA), conseguiram criar, pela primeira vez, embriões a partir de células humanas fertilizadas com espermatozoides.
Tentativa e erro
Não é impossível
Somente seis dias
A ovelha Dolly
Devemos fazer isso?
Por outro lado, especialistas afirmam que, embora seja um avanço notável, deve haver um debate aberto coma população sobre o que a ciência pode tornar possível.
(Direitos autorais reservados: https://www.msn.com/pt-br/noticias/noticias – The Daily Digest/ NOTÍCIAS/ por História de